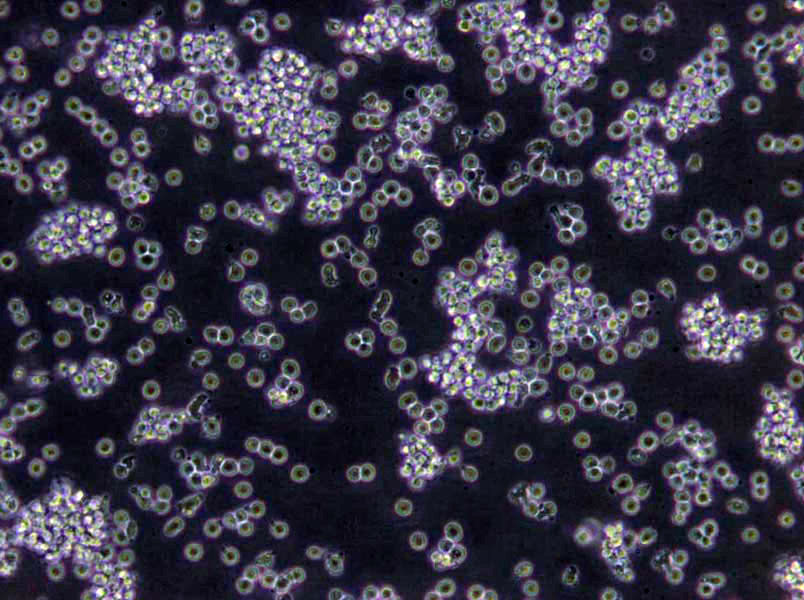
M17肉汤基础培养基

"M17肉汤基础培养基
产品规格:250g/瓶
英文名称:M17 Broth
消毒:消灭病原菌和有害微生物的营养体;灭菌:杀灭一切微生物的营养体,芽胞和孢子。方法:一、物理的方法:加热、过滤、辐射;二、化学的方法:用化学试剂抑制或杀灭微生物。主要破坏细菌代谢机能。如重金属离子,磺胺类药物及抗生素等。加热法:(1)干热法:火焰灼烧灭菌和热空气灭菌。1、火焰灼烧适用于接种环、接种针和金属用具如镊子等,试管口和瓶口,涂布用玻璃棒。2、热空气灭菌利用高温干燥空气(160-170C)加热灭菌1-2h,适用于玻璃器皿和培养皿等。原理加热使蛋白质变性,与水的含量有关,当环境和细胞含水量越大,凝固越快。3、注意事项:1)培养基、橡胶制品、塑料制品不能用此法;2)温度控制在<180°;3)物品不能太挤;4)温度降至70°时才开箱门。(2)湿热法:原理:因为湿热中菌体吸水,蛋白质容易凝固,因蛋白质含水量增加,所需凝固温度降低;湿热的蒸气有潜热存在。所以效果比同温度下干热好。
硫酸亚铁琼脂培养基英文名称:Ferrous sulfate Agar
山梨醇麦康凯琼脂培养基英文名称:Sorbitol MacConkey Agar (CT-SMAC Agar Base)
DTM培养基英文名称:Dermatophyte Test Medium Base
LB琼脂培养基[Lennox]英文名称:LB Agar,Lennox
产品用途:用于牛奶和乳制品中乳酸菌的检测,每100ml添加1支10%乳糖溶夜
M17肉汤基础培养基
微生物培养基的分类:1、按照培养基用途分为培养基按其特殊用途可分为加富培养基、选择性培养基和鉴别培养基。2、按照培养基的成分来分:培养基按其所含成分,可分为合成培养基、天然培养基和半合成培养基三类。合成培养基:合成培养基的各种成分完全是已知的各种化学物质。这种培养基的化学成分清楚,组成成分精确,重复性强,但价格较贵,而且微生物在这类培养基中生长较慢。如高氏一号合成培养基、察氏(Czapek)培养基等。天然培养基:由天然物质制成,如蒸熟的马铃薯和普通牛肉汤,前者用于培养霉菌,后者用于培养细菌。这类培养基的化学成分很不恒定,也难以确定,但配制方便,营养丰富,培养效果好,所以常被采用。半合成培养基:在天然有机物的基础上适当加入已知成分的无机盐类或在合成培养基的基础上添加某些天然成分,如培养霉菌用的马铃薯葡萄糖琼脂培养基。这类培养基能更有效地满足微生物对营养物质的需要。3、按照培养基的物理状态分:培养基按其物理状态可分为固体培养基、夜体培养基和半固体培养基三类。固体培养基:是在培养基中加入凝固剂,有琼脂、明胶、硅胶等。固体培养基常用于微生物分离、鉴定、计数和菌种保存等方面。用于微生物分离,鉴定,计数。如图,微生物分离成菌落、菌苔。图中为大肠杆菌菌落,是用涂布平板法得到。半固体培养基:是在夜体培养基中加入少量凝固剂而呈半固体状态。可用于观察细菌的运动、鉴定菌种和测定噬菌体的效价等方面。用于观察微生物运动特征。如图,左侧试管中微生物不运动,而右侧试管中微生物运动,因而两试管中现象不同。夜体培养基:夜体培养基中不加任何凝固剂。这种培养基的成分均匀,微生物能充分接触和利用培养基中的养料,适于作生理等研究,由于发酵率高,操作方便,也常用于发酵工业。用于观察微生物生长状态。3、按照微生物的种类分:培养基按微生物的种类可分为细菌培养基、放线菌培养基、酵母菌培养基和霉菌培养基等四类
TYC琼脂培养基英文名称:Tryptone Yeast Cystine Agar Medium
EF-18琼脂培养基英文名称:EF-18 Agar Base
YPD肉汤培养基英文名称:YPD Broth
SOB培养基英文名称:SOB Medium
硅酸盐细菌培养基英文名称:Silicate Bacteria Medium
使用说明:称取本品3.g于95ml蒸馏水或去离子水中,加热煮沸至完全溶解,分装121℃高压灭菌15分钟,冷至50℃,无菌操作加入无菌的10%乳糖溶夜5ml,混匀,备用。
公司提供预罐装平板培养基、预灌装试管培养基(15*150)、小管装培养基、干粉培养基、培养基添加剂、微生物检测配套试剂、显色培养基、培养基、生化鉴定管、植物组织培养基、标准菌株、GMP车间监测用培养基、模拟灌装用干粉培养基、中国药典2010版培养基、中国药典2015版培养基、药典(USP)培养基、欧洲药典(EP)培养基、英国药典(BP)培养基、日本药典(JP)培养基、中国兽药典培养基、医疗机构消毒技术规范培养基、国家消毒技术规范用培养基、食品安全国家标准GB4789、矿泉水检验—GB/T 8538、生活饮用水—GB/T5750、饲料检验用培养基—GB/T、其它GB标准用培养基、SN/T检验检疫行业标准、其它SN标准用培养基、化妆品检验用培养基、ISO标准系列培养基、培养基原材料等培养基产品。公司拥有多达600种微生物培养基配方、原理、用法、质量控制,涵盖所有常检细菌及其他细菌,涉及食品卫生检验、 医药、水质、临床、化妆品等各个领域、为您提供最详尽的微生物培养基相关知识。
Elliker肉汤培养基;英文名称:Elliker Broth;产品别名:Elliker肉汤培养基基础;Elliker肉汤培养基;使用说明:称取本品48.5g于1L蒸馏水或去离子水中,加热煮沸至完全溶解,分装,121℃灭菌15分钟,冷却,备用;产品规格:250g/瓶;产品用途:用于乳酸杆菌、乳酸链球菌的培养
赖安酸脱羧酶试验培养基;英文名称:Lysine-decarboxylase Test Medium;产品别名:赖安酸脱羧酶试验培养基基础;赖安酸脱羧酶试验培养基;使用说明:称取本品14.0g于1L蒸馏水或纯化水中,加热煮沸至完全溶解,分装小试管,每管滴加1层约0.5ml夜体石蜡,116℃高压灭菌10分钟或115℃灭菌15分钟,备用;产品规格:100g/瓶;产品用途:用于细菌的赖安酸脱羧酶试验
沙氏葡萄糖琼脂培养基[含抗生素];英文名称:Sabouraud-glucose Agar with antibiotics;产品别名:沙氏葡萄糖琼脂培养基基础[含抗生素];沙氏葡萄糖琼脂培养基[含抗生素];使用说明:称取本品65.0g于1L蒸馏水或去离子水中,加热煮沸至完全溶解,分装,121℃高压灭菌15分钟或115℃灭菌30分钟,灭菌结束后请摇匀,以防琼脂沉积于器皿底部而凝固,备用;产品规格:250g/瓶;产品用途:用于霉菌、酵母菌的分离和培养
PTM1[微量元素]培养基;英文名称:PTM1;产品别名:PTM1[微量元素]培养基基础;PTM1[微量元素]培养基;使用说明:称取本品94.9g于1L蒸馏水或去离子水中,搅拌均匀后加入5ml浓硫酸,加热煮沸溶解,冷却,过滤除菌,备用;产品规格:100g/瓶;产品用途:用于酵母菌的表达,需添加浓硫酸
Fraser肉汤增菌夜培养基;英文名称:Fraser Enrichment Broth Base;产品别名:Fraser肉汤增菌夜培养基基础;Fraser肉汤增菌夜培养基;使用说明:称取本品55.0g于1L蒸馏水或去离子水中,微温溶解,分装,121℃高压灭菌15分钟,冷却至40-50℃,每100ml培养基添加黄溶夜、萘啶酮酸溶夜各1支组成Fraser,每225ml培养基添加黄溶夜、萘啶酮酸溶夜、柠檬酸铁铵溶夜各1支组成Half-Fraser,备用;产品规格:250g/瓶;产品用途:用于李斯特氏菌增菌
厌氧肉汤培养基;英文名称:Anaerobe Basal Broth;产品别名:厌氧肉汤培养基基础;厌氧肉汤培养基;使用说明:称取本品35.4g于1L蒸馏水或去离子水(也可按比例增加或减少配制量),加热煮沸使溶解,分装,121℃高压灭菌15分钟,备用;产品规格:250g/瓶;产品用途:用于厌氧菌尤其是拟杆菌的培养
木糖-明胶培养基;英文名称:Xylose-Gelatin Medium;产品别名:木糖-明胶培养基基础;木糖-明胶培养基;使用说明:称取本品15.5克,加热溶解于100ml蒸馏水中,分装试管,115℃高压灭菌15分钟,迅速冷却,备用;产品规格:250g/瓶;产品用途:用于明胶夜化试验
MS培养基[1/2蔗糖];英文名称:Murashige & Skoog Medium (1/2 Sucrose);产品别名:MS培养基基础[1/2蔗糖];MS培养基[1/2蔗糖];使用说明:称取本品26.42g于1L蒸馏水或去离子水中,调节pH使灭菌后pH5.8±0.1(25℃),分装,115℃高压灭菌30分钟,灭菌结束后请摇匀,以防琼脂沉积于器皿底部而凝固,备用;产品规格:500g/瓶;产品用途:含琼脂,蔗糖15g/L,用于植物组织培养
乳糖莫能霉素葡萄糖醛酸琼脂培养基;英文名称:LMG Agar;产品别名:乳糖莫能霉素葡萄糖醛酸琼脂培养基基础;乳糖莫能霉素葡萄糖醛酸琼脂培养基;使用说明:称取本品46.3g,加热溶解于1000ml蒸馏水中,冷至50℃左右时,倾入无菌平皿,备用;产品规格:250g/瓶;产品用途:用于大肠菌群滤膜法检测
含糖牛肉汤培养基;英文名称:Beef soup Medium with Lactose;产品别名:含糖牛肉汤培养基基础;含糖牛肉汤培养基;使用说明:称取本品38g于1L蒸馏水或去离子水中,搅拌煮沸溶解,分装,115℃灭菌20分钟,冷却,备用;产品规格:250g/瓶;产品用途:用于乳酸菌培养和鉴别
MH肉汤培养基;英文名称:Mueller-Hinton Broth;产品别名:MH肉汤培养基基础;MH肉汤培养基;使用说明:称取本品21.0g于1L蒸馏水或去离子水中,煮沸溶解,分装,121℃高压灭菌15分钟,冷却,备用;产品规格:250g/瓶;产品用途:用于稀释法进行药敏试验
YPD琼脂培养基;英文名称:YPD Agar;产品别名:YPD琼脂培养基基础;YPD琼脂培养基;使用说明:称取本品65.0g于1L蒸馏水或去离子水中,加热煮沸至完全溶解,分装,121℃高压灭菌15分钟,灭菌结束后请摇匀,备用;产品规格:250g/瓶;产品用途:用于分子生物学实验中酵母菌的培养和保存
苛养厌氧菌琼脂培养基;英文名称:Fastidious Anaerobe Agar (FAA);产品别名:苛养厌氧菌琼脂培养基基础;苛养厌氧菌琼脂培养基;使用说明:称取本品45.7g于1L蒸馏水或去离子水中,加热煮沸至完全溶解,分装,121℃高压灭菌15分钟,灭菌结束后请摇匀,以防琼脂沉积于器皿底部而凝固,备用。本品有少许黑色不溶物;产品规格:250g/瓶;产品用途:用于厌氧菌的培养
结晶紫中性红胆盐葡萄糖琼脂培养基;英文名称:Violet Red Bile Dextrose Agar;产品别名:结晶紫中性红胆盐葡萄糖琼脂培养基基础;VRBDA培养基;结晶紫中性红胆盐葡萄糖琼脂培养基(VRBDA);使用说明:称取本品39.5g,加热溶解于1000ml蒸馏水中,煮沸不要超过2分钟,冷至50℃左右时,倾入无菌平皿。无需高压灭菌;产品规格:250g/瓶;产品用途:肠道菌计数琼脂,不含乳糖,用于肠道菌分离和计数
自诱导LB肉汤培养基;英文名称:Autoinduction Luria-Bertani Broth Medium;产品别名:自诱导LB肉汤培养基基础;自诱导LB肉汤培养基;使用说明:NULL;产品规格:250g/瓶;产品用途:用于重组蛋白的表达,需添加
Cl化钠多粘菌素B肉汤培养基;英文名称:Sodium Chloride Polymyxin Broth Base;产品别名:Cl化钠多粘菌素B肉汤培养基基础;SPB培养基;Cl化钠多粘菌素B肉汤培养基(SPB);使用说明:称取本品33克,加入1000ml蒸馏水中,混合后加热溶解,分装于三角瓶中,每瓶100ml,121℃15分钟高压灭菌,冷至50℃以下每100ml基础培养基中,加入1支多粘菌素B25000单位,混匀,无菌分装于灭菌试管;产品规格:250g/瓶;产品用途:用于副溶血性弧菌选择性增菌,每100ml添加1支多粘菌素B(2.5万单位)
抗生素培养基F[PH6.1];英文名称:Medium F(PH6.1);产品别名:抗生素培养基基础F[PH6.1];抗生素培养基F[PH6.1];使用说明:NULL;产品规格:250g/瓶;产品用途: 用于抗生素鉴定
抗生素培养基10号;英文名称:Medium 10(Polymyxin Seed Agar);产品别名:抗生素培养基基础10号;抗生素培养基10号;使用说明:称取本品42.0g,另取10g吐温80,加热溶解于1000ml纯化水中,分装,121℃高压灭菌15分钟,备用;产品规格:250g/瓶;产品用途:用于微生物方法测定抗生素效价,每100ml添加1支吐温80
Br紫葡萄糖蛋白胨培养基;英文名称:Glucose Peptone Medium;产品别名:Br紫葡萄糖蛋白胨培养基基础;Br紫葡萄糖蛋白胨培养基;使用说明:称取本品15.0g,加热搅拌溶解于1000ml蒸馏水中,115℃高压灭菌30分钟,备用;产品规格:250g/瓶;产品用途:用于鲜乳中抗生素残留检验
改良DG-18琼脂培养基;英文名称:Dichloran Glycerol Agar Base,Modified;产品别名:改良DG-18琼脂培养基基础;改良DG-18琼脂培养基;使用说明:称取本品32.5g于1L蒸馏水或去离子水中,加热煮沸至完全溶解,加入220g,摇匀,分装,121℃高压灭菌15分钟,灭菌结束后请摇匀,以防琼脂沉积于器皿底部而凝固,备用;产品规格:250g/瓶;产品用途:用于霉菌酵母菌的计数,每升培养基中添加220g
KF链球菌肉汤培养基;英文名称:KF Streptococcus Broth;产品别名:KF链球菌肉汤培养基基础;KF链球菌肉汤培养基;使用说明:MPN法检测时,若接种量为1ml或更少,称取本品56.4g于1L蒸馏水或去离子水中,加热溶解,10ml/支分装;若接种量为10ml,称取本品84.6g于1L蒸馏水或去离子水中,加热溶解,20ml/支分装,121℃灭菌10分钟,冷却备用。膜过滤法检测时,称取本品56.4g于1L蒸馏水或去离子水中,加热溶解,分装, 121℃灭菌10分钟,冷却至60℃左右,每100ml培养基添加1支1%TTC溶夜,混匀,倾注平皿;产品规格:250g/瓶;产品用途:用于肠球菌、链球菌计数和检验,视须要每100ml培养基添加1支1%TTC溶夜
胆汁夜态培养基;英文名称:Bile Broth Medium;产品别名:胆汁夜态培养基基础;胆汁夜态培养基;使用说明:称取本品.0于1L蒸馏水或去离子水中,加热溶解,分装试管,121℃高压灭菌15分钟,冷暗储存备用;产品规格:250g/瓶;产品用途:用于粪链球菌验证和培养
M17肉汤基础培养基
K氏培养基;英文名称:K’s Medium Base;产品别名:K氏培养基基础;K氏培养基;使用说明:称取本品24.5g于1L蒸馏水或去离子水中,加热煮沸至完全溶解,分装,121℃高压灭菌15分钟,灭菌结束后请摇匀,冷至55℃左右,无菌操作,加入灭菌的苹果酸约1.5g/L使pH降至3.7,混匀,倾注平板,凝固,备用。本品潮湿易结块,不影响使用;产品规格:250g/瓶;产品用途:用于饮料中耐热耐酸菌的检测,需使用苹果酸调节pH
Wilkins-Chalgren厌氧菌肉汤培养基;英文名称:Wilkins-Chalgren Anaerobe Broth;产品别名:Wilkins-Chalgren厌氧菌肉汤培养基基础;Wilkins-Chalgren厌氧菌肉汤培养基;使用说明:称取本品33.0g于1L蒸馏水或去离子水中,加热煮沸至完全溶解,分装,121℃高压灭菌15分钟或115℃灭菌30分钟,冷却,备用;产品规格:250g/瓶;产品用途:用于厌氧菌的培养和药敏试验
咖啡酸琼脂培养基;英文名称:Caffeic Acid Agar;产品别名:咖啡酸琼脂培养基基础;CAA培养基;咖啡酸琼脂培养基(CAA);使用说明:NULL;产品规格:500g/瓶;产品用途:用于新生隐球菌及其他隐球菌的培养
黄豆粉琼脂培养基;英文名称:Bean Agar Medium;产品别名:黄豆粉琼脂培养基基础;黄豆粉琼脂培养基;使用说明:称取本品56.6g于1L蒸馏水或去离子水中(可按比例增加或减少配制量),加热煮沸至完全溶解,分装,121℃高压灭菌15分钟,灭菌结束后请摇匀,以防琼脂沉积于器皿底部而凝固,备用;产品规格:250g/瓶;产品用途:用于放线杆菌的筛选和培养
肝浸夜培养基;英文名称:Liver Infusion Broth;产品别名:肝浸夜培养基基础;肝汤;肝浸夜培养基;使用说明:称取本品21.0克,溶解于1000ml蒸馏水中,分装于18×150mm试管内,并加入牛肝粒(1-2cm厚),121℃高压灭菌20分钟以上,冷却备用;产品规格:250g/瓶;产品用途:用于嗜热芽孢菌的鉴别培养,需添加牛肝粒牛肝粒
BBL琼脂培养基;英文名称:BBL Agar Medium;产品别名:BBL琼脂培养基基础;双歧杆菌琼脂培养基;BBL琼脂培养基;使用说明:称取本品69.3g于1L蒸馏水或去离子水中,加热煮沸至完全溶解,分装,121℃高压灭菌15分钟,灭菌结束后请摇匀,以防琼脂沉积于器皿底部而凝固,备用;产品规格:250g/瓶;产品用途:用于双歧杆菌分离培养
EF-18琼脂培养基;英文名称:EF-18 Agar Base;产品别名:EF-18琼脂培养基基础;EF-18琼脂培养基;使用说明:称取本品5.38g于100ml蒸馏水或去离子水中,加热煮沸1分钟使完全溶解,冷至50℃左右,每100ml培养基添加1支新生霉素1.5mg,混匀,倾注平板凝固,备用;产品规格:250g/瓶;产品用途:用于沙门氏菌滤膜法检验,每100ml中添加1支新生霉素溶夜
西蒙氏柠檬酸盐琼脂培养基;英文名称:Simmons Citrate Agar;产品别名:西蒙氏柠檬酸盐琼脂培养基基础;枸橼酸盐琼脂;西蒙氏柠檬酸盐琼脂培养基;使用说明:称取本品32.3g于1L蒸馏水或去离子水中,加热煮沸至溶解,分装试管,121℃高压灭菌15分钟,摆斜面,凝固,备用;产品规格:250g/瓶;产品用途:用于柠檬酸盐利用实验
AA夜体培养基;英文名称:AA Fluid Medium;产品别名:AA夜体培养基基础;AA夜体培养基;使用说明:称取本品22.7g于1L蒸馏水或去离子水中,使用NaOH或HCl调节pH使灭菌后pH5.7-5.9(25℃),煮沸溶解,分装,115℃高压灭菌30分钟,备用。本品为可能有少量不溶物;产品规格:500g/瓶;产品用途:用于愈伤组织悬浮培养
Hayflick培养基;英文名称:Hayflick Medium;产品别名:Hayflick培养基基础;Hayflick培养基;使用说明:NULL;产品规格:250g/瓶;产品用途:需添加马血清、青霉素和
Iso-Sensitest肉汤培养基;英文名称:Iso-Sensitest Broth;产品别名:Iso-Sensitest肉汤培养基基础;Iso-Sensitest肉汤培养基;使用说明:称取本品23.4g于1L蒸馏水或去离子水中,煮沸溶解,分装,121℃高压灭菌15分钟,备用。本品为可能有少量不溶物;产品规格:10L/瓶;产品用途:用于抗生素药敏试验
酪胨-大豆卵磷脂-吐温20夜体培养基;英文名称:Fluid Casein Digest-Soy Lecithin-Polysorbate 20 Me;产品别名:酪胨-大豆卵磷脂-吐温20夜体培养基基础;酪胨-大豆卵磷脂-吐温20夜体培养基;使用说明:称取本品25.0g于960ml纯水或去离子水中,加入40ml吐温20,48-50℃水浴30分钟溶解,分装,121℃高压灭菌15分钟,备用;产品规格:250g/瓶;产品用途:用于药品稀释,每升培养基需添加40ml吐温20
Br紫平板计数琼脂培养基;英文名称:Plate Count Agar with BCP;产品别名:Br紫平板计数琼脂培养基基础;Br紫平板计数琼脂培养基;使用说明:称取本品24.7g于1L蒸馏水或去离子水中,加热煮沸至完全溶解,分装,121℃高压灭菌15分钟,灭菌结束后请摇匀,以防琼脂沉积于器皿底部而凝固,备用;产品规格:250g/瓶;产品用途:用于乳酸菌总数测定
酵母粉葡萄糖Cl霉素琼脂培养基;英文名称:Yeast Extract Glucose Chloramphenicol Agar;产品别名:酵母粉葡萄糖Cl霉素琼脂培养基基础;YGC培养基;酵母粉葡萄糖Cl霉素琼脂培养基(YGC);使用说明:称取本品40.0g于1L蒸馏水或去离子水中,加热煮沸至完全溶解,分装,121℃灭菌15分钟,倾注平板,凝固,备用;产品规格:250g/瓶;产品用途:用于霉菌酵母菌的分离和计数
含0.6%酵母浸膏的胰酪胨大豆琼脂培养基;英文名称:Trypticase Soy-Yeast Extract Agar;产品别名:含0.6%酵母浸膏的胰酪胨大豆琼脂培养基基础;TSA-YE培养基;含0.6%酵母浸膏的胰酪胨大豆琼脂培养基(TSA-YE);使用说明:称取本品51.0g于1L蒸馏水或去离子水中,加热煮沸至完全溶解,分装,121℃高压灭菌15分钟,灭菌结束后请摇匀,倾注平板,凝固,备用;产品规格:250g/瓶;产品用途:用于单核增生李斯特氏菌的纯化培养
抗生素培养基A[PH7.9];英文名称:Medium A(PH7.9);产品别名:抗生素培养基基础A[PH7.9];抗生素培养基A[PH7.9];使用说明:称取本品30.5g于1L蒸馏水或去离子水中,加热煮沸至完全溶解,分装,121℃高压灭菌15分钟或115℃灭菌30分钟,灭菌结束后请摇匀,以防琼脂沉积于器皿底部而凝固,备用;产品规格:250g/瓶;产品用途:用于抗生素检测
酵母霉菌琼脂培养基;英文名称:Yeast Mold Agar;产品别名:酵母霉菌琼脂培养基基础;YM琼脂培养基;酵母霉菌琼脂培养基(YM);使用说明:称取本品1.43g于900ml去离子水中,另称取配套硝酸钙0.5g于100ml去离子水中,搅拌溶解,混合,视需要加入蔗糖、琼脂等物质,使用NaOH或HCl调节pH使灭菌后pH5.7-5.9(25℃),煮沸溶解,分装,115℃高压灭菌30分钟,备用。本品可能有少量不溶物;产品规格:250g/瓶;产品用途:用于霉菌、酵母菌和其它耐酸菌的培养
Rogosa SL琼脂培养基;英文名称:Rogosa SL Agar;产品别名:Rogosa SL琼脂培养基基础;Rogosa SL琼脂培养基;使用说明:称取本品.7g于1L蒸馏水或去离子水中,煮沸溶解1分钟,加入1ml吐温80和1.32ml,校正pH至5.4±0.2(25℃) ,继续煮沸2-3分钟,备用;产品规格:100g/瓶;产品用途:用于口腔、阴道和粪便中乳酸杆菌的检验,每升添加1.32ml冰乙酸和1ml吐温80
改良EC肉汤培养基[mEC+n];英文名称:Modified EC Broth Base;产品别名:改良EC肉汤培养基基础[mEC+n];改良EC肉汤培养基[mEC+n];使用说明:称取本品36.6g于1L蒸馏水或去离子水中,微温溶解,分装,121℃高压灭菌15分钟,冷至50℃以下,无菌操作每225ml中添加1支新生霉素储备夜,每100ml中添加1支新生霉素储备夜,混匀,备用;产品规格:250g/瓶;产品用途:用于O157选择性增菌,每225ml中添加1支新生霉素储备夜,每100ml中添加1支新生霉素储备夜
XLT4琼脂培养基;英文名称:XLT4 Agar;产品别名:XLT4琼脂培养基基础;XLT4琼脂培养基;使用说明:称取本品55.2g,加热溶解于1000ml蒸馏水中,冷至50℃左右时,倾入无菌平皿,备用;产品规格:250g/瓶;产品用途:用于沙门氏菌等肠道致病菌的选择性分离
营养盐培养基;英文名称:Nutrient Salt Broth;产品别名:营养盐培养基基础;营养盐培养基;使用说明:称取本品34.0g于1L含0.05%润湿剂(如吐温80、N-甲基乙磺酸或二辛磺化丁二酸钠)的蒸馏水或去离子水中(可按比例增加或减少配制量),加热煮沸至完全溶解,分装,115℃高压灭菌30分钟,备用。本品有大量不溶物,分装时请混匀;产品规格:250g/瓶;产品用途:用于抗菌性能试验,每升培养基中添加0.5g吐温-80
胰化大豆硫酸镁琼脂培养基;英文名称:TSAM Agar;产品别名:胰化大豆硫酸镁琼脂培养基基础;TSAM培养基;胰化大豆硫酸镁琼脂培养基(TSAM);使用说明:称取本品41.5g于1L蒸馏水或去离子水中,加热煮沸至完全溶解,分装,121℃高压灭菌15分钟,灭菌结束后请摇匀,以防琼脂沉积于器皿底部而凝固,备用;产品规格:250g/瓶;产品用途:用于大肠菌群滤膜法检测
无盐麦康凯琼脂培养基;英文名称:MacConkey Agar Without Salt;产品别名:无盐麦康凯琼脂培养基基础;无盐麦康凯琼脂培养基;使用说明:称取本品47.3g,加热溶解于1000ml蒸馏水中,121℃高压灭菌15分钟,备用;产品规格:250g/瓶;产品用途:用于尿夜中变形杆菌和大肠埃希氏菌的分离
发根农杆菌夜体培养基;英文名称:Agrobacterium rhizogene Broth Medium;产品别名:发根农杆菌夜体培养基基础;发根农杆菌夜体培养基;使用说明:称取本品16.5g于1L蒸馏水或去离子水中(可按比例增加或减少配制量),加热煮沸至完全溶解,分装,121℃高压灭菌15分钟,冷却,备用。如有需要,冷却后,无菌操作添加过滤除菌的抗生素溶夜(如卡那霉素100mg/L),混匀,备用;产品规格:250g/瓶;产品用途:用于发根农杆菌的培养
山梨醇麦康凯半固体培养基;英文名称:Sorbitol MacConkey Semi-solid Medium;产品别名:山梨醇麦康凯半固体培养基基础;山梨醇麦康凯半固体培养基;使用说明:NULL;产品规格:250g/瓶;产品用途:用于大肠埃希氏菌O157菌种保存
抗生素检测用培养基Ⅱ;英文名称:Antibiotic Examination Medium Ⅱ;产品别名:抗生素检测用培养基基础Ⅱ;抗生素检测用培养基Ⅱ;使用说明:称取本品36.0g,加热溶解于1000ml蒸馏水中,分装,121℃高压灭菌15分钟,备用;产品规格:250g/瓶;产品用途:用于乳及乳制品中舒巴坦敏感β-内酰胺酶类药物检验
抗生素培养基4号;英文名称:Medium 4(Yeast Beef Agar);产品别名:抗生素培养基基础4号;抗生素培养基4号;使用说明:称取本品60.0g,加热溶解于1000ml纯化水中,分装,115℃高压灭菌30分钟,备用;产品规格:250g/瓶;产品用途:用于微生物方法测定抗生素效价
酵母安基酸缺陷型合成琼脂培养基[尿嘧啶缺陷/SC-Ura];英文名称:Yeast Synthetic Drop-out Agar Medium without Uraci;产品别名:酵母安基酸缺陷型合成琼脂培养基基础[尿嘧啶缺陷/SC-Ura];酵母安基酸缺陷型合成琼脂培养基[尿嘧啶缺陷/SC-Ura];使用说明:称取本品0.862溶于20ml蒸馏水或去离子水中,视需要加入20g碳源,微温溶解,过滤除菌,2~8℃保存。另取1.2g琼脂粉于80ml水中,121℃ 高压灭菌15分钟。冷至55℃左右,混合,轻轻摇匀,倾注平皿,备用;产品规格:250g/瓶;产品用途:用于酵母杂交及遗传突变株的筛选和研究
改良高氏合成一号夜体培养基;英文名称:Gauze’s Synthetic Broth Medium,Modified;产品别名:改良高氏合成一号夜体培养基基础;改良高氏合成一号夜体培养基;使用说明:称取本品22.5g于1L蒸馏水或去离子水中,煮沸溶解1分钟,补水至1000ml,分装,121℃灭菌15分钟,冷至55℃,视需求每300ml培养基中选择性添加3%重溶夜1ml以增加抑菌性,混匀,冷却,备用;产品规格:250g/瓶;产品用途:用于放线菌的培养
Starky硫代硫酸钠琼脂培养基;英文名称:Starky -Na2S2O3 Agar Medium;产品别名:Starky硫代硫酸钠琼脂培养基基础;Starky硫代硫酸钠琼脂培养基;使用说明:NULL;产品规格:250g/瓶;产品用途:用于氧化硫硫杆菌的培养
伊红美蓝琼脂培养基[不含乳糖];英文名称:Levine’s Eosin-Methylene Blue Agar without Lactose;产品别名:伊红美蓝琼脂培养基基础[不含乳糖];伊红美蓝琼脂培养基[不含乳糖];使用说明:称取本品27.5g于1L蒸馏水或去离子水中(可按比例增加或减少配制量),加热煮沸1分钟使完全溶解,121℃灭菌15分钟,冷至55℃左右,倾注平皿,冷却,备用;产品规格:250g/瓶;产品用途:大肠杆菌基因学研究
麸皮夜体培养基;英文名称:Wheat Bran Medium;产品别名:麸皮夜体培养基基础;麸皮夜体培养基;使用说明:NULL;产品规格:250g/瓶;产品用途:用于细菌、真菌的培养
CATC琼脂培养基;英文名称:CATC Agar;产品别名:CATC琼脂培养基基础;CATC琼脂培养基;使用说明:称取本品58.5g,加热煮沸溶解于1000ml蒸馏水中,冷至50~55℃时,倾入无菌平皿,备用。无需高压灭菌;产品规格:250g/瓶;产品用途:含TTC,用于肠球菌的分离和培养
B12琼脂培养基;英文名称:B12 Assay Medium;产品别名:B12琼脂培养基基础;B12琼脂培养基;使用说明:NULL;产品规格:250g/瓶;产品用途:用于维生素B12检测
Wilkins-Chalgren厌氧菌琼脂培养基;英文名称:Wilkins-Chalgren Anaerobe Agar;产品别名:Wilkins-Chalgren厌氧菌琼脂培养基基础;Wilkins-Chalgren厌氧菌琼脂培养基;使用说明:称取本品48.0g于1L蒸馏水或去离子水中,加热煮沸至完全溶解,分装,121℃高压灭菌15分钟或115℃灭菌30分钟,灭菌结束后请摇匀,以防琼脂沉积于器皿底部而凝固,备用;产品规格:250g/瓶;产品用途:用于厌氧菌的培养和药敏试验
胰酪大豆胨琼脂培养基;英文名称:Soybean-Casein Digest Agar Medium;产品别名:胰酪大豆胨琼脂培养基基础;无菌胰酪大豆胨琼脂培养基;大豆酪蛋白琼脂培养基;胰酪大豆胨琼脂培养基;使用说明:称取本品40.0g于1L蒸馏水或去离子水中,加热煮沸至完全溶解,分装,121℃高压灭菌15分钟或115℃灭菌30分钟,灭菌结束后请摇匀,以防琼脂沉积于器皿底部而凝固,备用;产品规格:250g/瓶;产品用途:用于无菌和细菌培养
气单胞菌培养基[Ryan]英文名称:Aeromonas Medium Base (Rayn)
气单胞菌培养基[Ryan]英文名称:Aeromonas Medium Base (Rayn)
抗生素培养基10号英文名称:Medium 10(Polymyxin Seed Agar)
TGYA培养基英文名称:Tryptone Glucose Yeast Agar
PLET琼脂培养基英文名称:PLET Agar Base
根瘤菌培养基[YM]英文名称:Nodule Bacteria Medium YM
布氏肉汤培养基英文名称:Brucella Broth
芽孢杆菌培养基英文名称:Bacillus Medium Base
牛心汤琼脂培养基英文名称:Cattle Heart Broth Agar
硫酸盐还原菌培养基E英文名称:Postgate’s Medium E for Sulfate Reducers
RV R10肉汤培养基英文名称:Rappaport-Vassiliadis R10 broth
葡萄糖半固体琼脂培养基英文名称:Dextrose Semisolid Agar
硫酸盐还原菌培养基E英文名称:Postgate’s Medium E for Sulfate Reducers
3%Cl化钠胰蛋白胨大豆琼脂培养基英文名称:3% NaCl Tryptone Soy Agar
Wort肉汤培养基英文名称:Wort Broth Base
蔗糖胰蛋白胨肉汤培养基英文名称:Sucrose Tryptone Broth
Skirrow琼脂培养基英文名称:Skirrow Agar Base
YPDA培养基英文名称:Yeast Peptone Dextrose Adenine Medium
大豆酪蛋白肉汤培养基英文名称:Fluid Soybean-Casein Digest Broth
月桂基硫酸盐胰蛋白胨肉汤培养基英文名称:Lauryl Sulfate Tryptose Broth
改良高氏合成一号琼脂培养基英文名称:Gauze’s Synthetic Agar Medium,Modified
TYA培养基英文名称:TYA Medium Base
Leeming-Notman培养基英文名称:Leeming-Notman Medium
Waksman夜体培养基英文名称:Waksman Medium
AA夜体培养基英文名称:AA Fluid Medium
去氧胆酸盐琼脂培养基英文名称:Desoxycholate Lactose Agar
麦芽糖酵母浸粉琼脂培养基英文名称:Maltose yeast extract agar (Okazaki and Okami, 197
酵母安基酸缺陷型合成夜体培养基[亮安酸/色安酸缺陷]英文名称:Yeast Synthetic Drop-out Fluid Medium
可溶性淀粉琼脂培养基英文名称:Soluble Starch Agar
M17肉汤基础培养基
PS琼脂培养基英文名称:Peptococcus Selective Agar
抗生素培养基F[PH6.0]英文名称:Medium F(PH6.0)
乙酰胺琼脂培养基英文名称:Acetamide Agar
3%Cl化钠三糖铁琼脂培养基英文名称:3% TSI Agar
不含糖平板计数琼脂培养基英文名称:Plate Count Agar without Dextrose
厌氧肉肝汤培养基英文名称:Anaerobic Meat Liver Broth
WL营养肉汤培养基英文名称:Wallerstein Laboratory Nutrient Broth
鸟安酸脱羧酶试验培养基英文名称:Ornithine Decarboxylase Test Medium
Br紫乳糖琼脂培养基英文名称:Purple Lactose Agar
改良平板计数琼脂培养基英文名称:Modified Plate Count Agar
NZCYM肉汤培养基英文名称:NZCYM Broth
煌绿乳糖胆盐肉汤培养基英文名称:Brilliant Green Lactose Bile Broth
营养琼脂培养基[pH6.0]英文名称:Nutrient Agar, pH6.0
BMGY/BMMY培养基英文名称:BMGY/BMMY Medium Base
改良巴尔斯氏培养基英文名称:Baar,s Medium for Sulfate Reducers, Modified
胰酪胨大豆多粘菌素肉汤培养基英文名称:Trypticase Soy Polymyxin Broth Base
胆盐乳糖培养基英文名称:Bile Lactose Medium
Luria琼脂培养基英文名称:Luria Agar Base
固氮螺菌培养基英文名称:Azospirillum Medium
EB肉汤增菌夜培养基英文名称:EB Enrichment Broth
强化梭菌鉴别琼脂培养基英文名称:Differentia Reinforced Clostridial Agar
赫奇逊夜体培养基英文名称:Hutchison Fluid Medium
"


![M17肉汤培养基[源头供货]](https://img.chemicalbook.com/SupplyImg1/2025-01-24/Large/202501241719332863227.jpg)